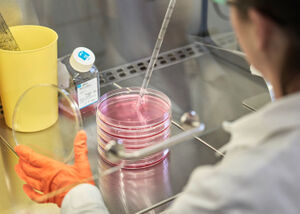

Stills
Klötzli Messerschmiede
Tina Gardi
«Le scorie di Monte Torri»
«Vogelperspektiven»
«atmóssphaira»
Januar Designbüro
«Luna»
«24»
Thermission AG
Grounding
Tina Gardi
Swiss Border Guard Knife
«The beauty of Jacquard Silk»
«Morphologie»
«Lichens»
«Burglind»
«Memento Mori»
Corporate
SBG 1 – Swiss Boarder Guard
Häfliger & Zaugg
University of Zurich
schön&gut
Rare & Fine Vintage Watches AG
Pfiffner AG
Albrecht Naturgarten
Restaurant Fischerstübli, Bern
Schwarzenbach Weinbau
schön&gut
Baumschulen Reichenbach
Swisspath AG
Corporate Portraits
Reportage
Timo Wenzel
Paula Rigendinger
Simone Gugger
Moritz Häberling AG
«Mademoiselle de Paris»
Klötzli Messerschmiede
Universität Zürich
ZRCL – Wollspinnerei Vetsch
Atelier Felber
Lipp Destillerie
Dafi Kühne
Schwarzenbach Weinbau
«Burglind»
«Wald»
«Atlantic»
Architecture
Kunsthaus Zürich
Kultur und Kongresszentrum Baden
Benediktinerkloster Disentis
Kantonsspital Luzern
Hochschule Luzern
Kloster Disentis
Pfiffner AG
Kantonsspital Uri
Roggerambauen AG
Union
Suurstoffi Rotkreuz
WR Architekten AG
École «Le-Sapay», Genf
«Haus C» St. Urban
Lassalle-Haus
Brunner Küchen AG